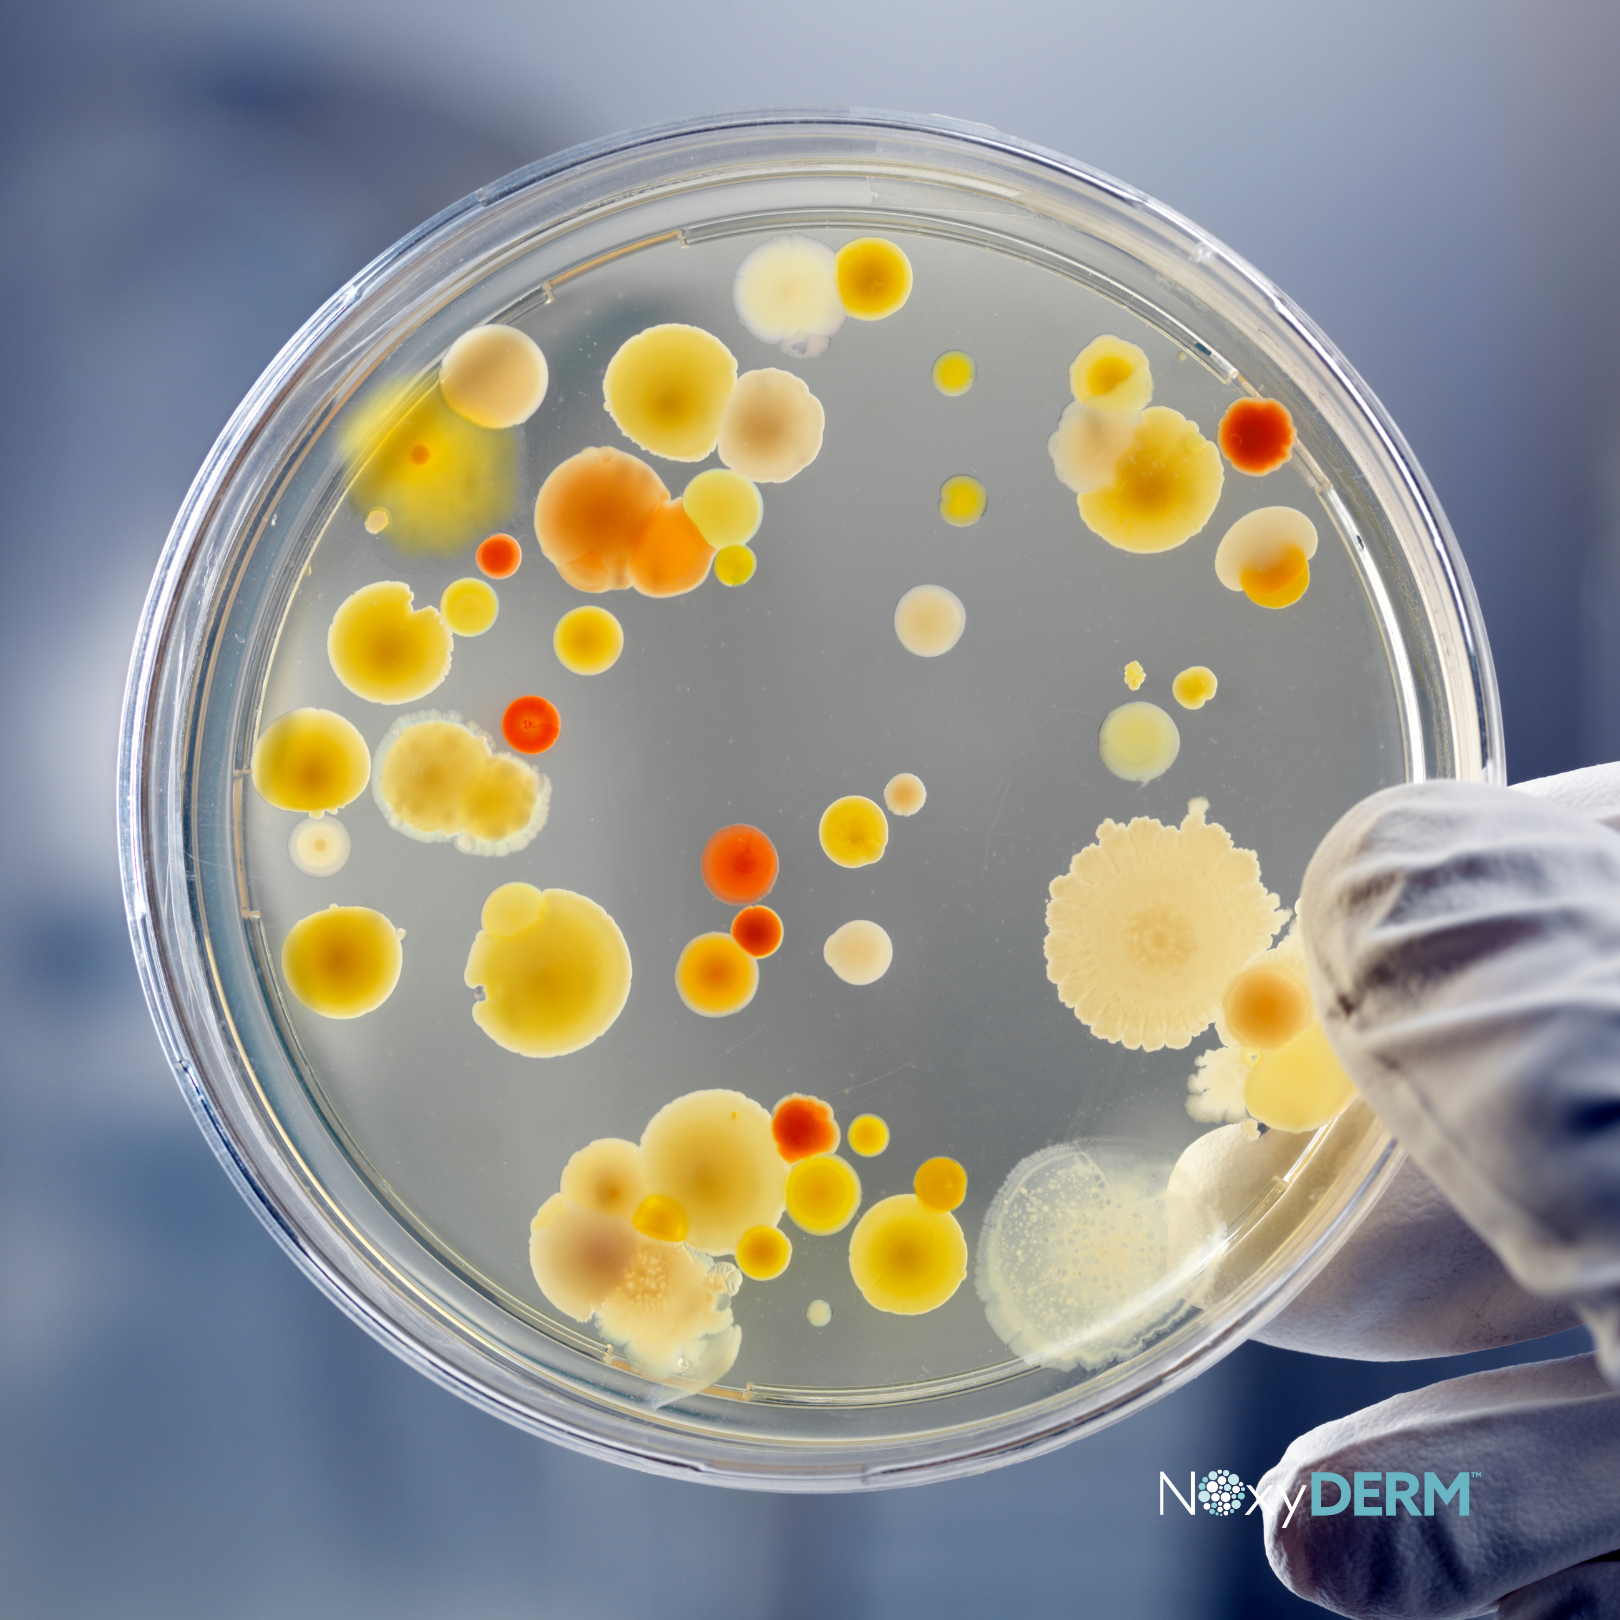

Premium Approach to At-Home First Aid

Prevent
Infection
Support Healthier-
Looking Skin
Promote
Recovery
Featured product

Elevated First Aid for Everyday Skin with NOxyDERM Wound Care Foam
- Helps prevent infection with benzalkonium chloride
- Nitric oxide supports healthier-looking skin during first aid care
- Gentle wound care foam designed for minor cuts and scrapes
- Simple use: pump, apply for 5 minutes, then rinse or wipe away
- About 10 treatments per bottle (3 pumps per use)
Pickup currently not available

The Power of NOxyDERM
Formulated with benzalkonium chloride, an FDA-approved first aid antiseptic, NOxyDERM not only supports wound recovery but also helps prevent infection. Trusted in leading skilled nursing facilities, NOxyDERM is backed by 15 patents and 15+ pending, reflecting a commitment to innovation and high-quality care.
What Our Customers Are Saying:
Shop HSA/FSA on Amazon
Looking to take advantage of your HSA/FSA cards or shop directly on Amazon? Click this button to shop now!

Prevent Infection
NOxyDERM is a powerful wound care solution designed to support the recovery of minor cuts, scrapes, and burns. Formulated with Benzalkonium Chloride, a trusted antiseptic used in medical products, NOxyDERM's simple and effective formula is built to prevent infection in minor wounds.
Support Healthier-Looking Skin
Nitric Oxide, sometimes called “nature’s miracle molecule,” is naturally produced in a healthy body and plays a role in normal skin function. NOxyDERM’s foam formulation releases Nitric Oxide when pumped, allowing it to be applied directly to minor cuts, scrapes, burns, and wounds. By supporting the skin’s natural processes, this formula helps promote the appearance of healthier-looking skin as the body recovers.

Subscribe to our emails
Be the first to know about special offers and wound care tips!